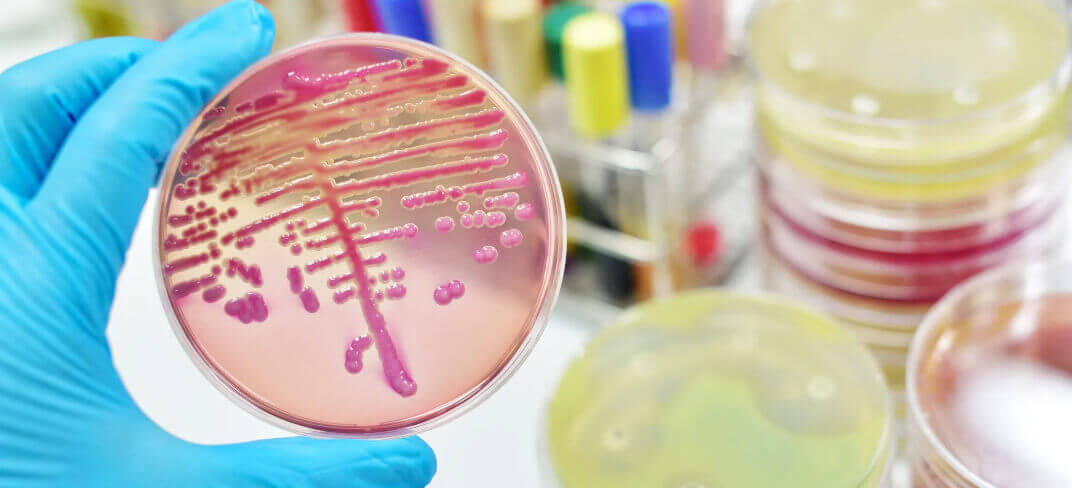
Get to Know the Signs and Symptoms of Sepsis | UPMC Ireland

Get to Know the Signs and Symptoms of Sepsis
Have you heard of the silent killer? It can strike people of any age, often without any notice. And rates are increasing every year.
That silent killer is sepsis. Most people have never heard of sepsis. They have no idea what it is or what to do about it.
But knowing the signs of sepsis could save your life or the life of someone you love.
What Is Sepsis?
Sepsis is a severe response of the body to an infection. When the immune system fights an infection, it releases chemicals into the blood to combat it. However, in some cases, these chemicals can trigger widespread inflammation, damaging multiple organs and systems in the body.
In the most severe cases, sepsis can lead to the malfunction of one or more organs. If the condition worsens, blood pressure drops, the heart weakens, and septic shock sets in, a situation where vital organs like the lungs, kidneys, and liver can quickly fail.
Septic shock is extremely dangerous, with a mortality rate reaching 50% of cases. The key to avoiding it is recognising symptoms early and receiving immediate treatment.
What Are the Two Stages of Sepsis?
Sepsis develops in two main stages: sepsis and septic shock.
Sepsis
The early symptoms of sepsis may appear mild or resemble those of other less severe conditions.
Doctors diagnose sepsis when at least two of the following symptoms are present:
- Fever above 38°C
- Heart rate above 90 beats per minute
- Respiratory rate above 20 breaths per minute
- Presence of a suspected or confirmed infection
This stage is also known as Systemic Inflammatory Response Syndrome (SIRS).
Septic shock
Septic shock is the most severe phase of sepsis and occurs when blood pressure remains dangerously low despite adequate fluid administration.
Symptoms of septic shock include:
- Accelerated heart rate
- Dizziness
- Abnormally low body temperature
- Rapid breathing
Receiving timely treatment is crucial: every hour of delay significantly reduces survival chances. Even with proper care, septic shock can leave permanent consequences, such as organ damage or long-term complications.
Causes of Sepsis
Sepsis can arise from any type of infection in the body, although most infections can be resolved with timely and appropriate treatment. The most common cause of sepsis is bacterial infection.
However, some infections have a higher likelihood of progressing to sepsis, including:
- Pneumonia and other respiratory infections
- Bloodstream infections
- Urinary tract infections
- Lung, skin, kidney, or abdominal infections
Only a small percentage, around 2% to 4%, of sepsis cases are caused by viral, fungal, or parasitic infections. To diagnose sepsis, the doctor will assess the symptoms and may perform a series of tests, including blood tests, X-rays, or CT scans, to identify the source of the infection and the severity of the condition.
Risk Factors
People at higher risk of sepsis include:
- Adults over 65 years old, especially those with chronic diseases such as diabetes or hypertension.
- Individuals with chronic health conditions, including diabetes, kidney, liver, and lung diseases.
- People with diseases that weaken the immune system, such as HIV/AIDS or cancer.
- Pregnant women.
- Newborns, especially those born prematurely or with low birth weight.
- Patients in intensive care or those who are intubated.
The risk of sepsis also increases in cases of:
- Steroid medication use.
- Severe burns.
- Severe physical trauma.
- Prolonged use of catheters.
- Dialysis.
Symptoms
Diagnosing sepsis in its early stages can be challenging because its symptoms can resemble those of other common conditions. For this reason, doctors look for the presence of at least two or more of the following symptoms before making a sepsis diagnosis:
- Accelerated heart rate (over 90 beats per minute).
- Rapid breathing (over 20 breaths per minute).
- Presence of an infection (which can be confirmed through blood tests showing a low white blood cell count).
- Abnormal body temperature (above 38°C or below 36°C).
In addition to these, there are other symptoms that may indicate sepsis, including:
- Feeling confused.
- Shivering or chills.
- Moist or sweaty skin.
- Shortness of breath.
- Extreme fatigue and general malaise.
- Intense pain.
If any of these symptoms occur, it is crucial to seek emergency medical care immediately.
The Progression of Sepsis: How Long Does It Take to Develop?
The timing of sepsis can vary from person to person. Sepsis can manifest very quickly after the onset of an infection, sometimes within 24 hours, but it can also develop long after the infection has started.
Once symptoms appear, the patient must be treated as soon as possible. Some infections need to be treated within one or two hours of the first symptoms to prevent long-term organ damage.
Treatment of Sepsis
The treatment of sepsis begins with eliminating the infection that caused it, usually through antibiotics to combat bacterial infections. If the infection is viral or fungal in nature, doctors will adjust the treatment with specific medications. Acting quickly is crucial to improving survival chances and preventing permanent organ damage.
To manage sepsis, medical staff may use various therapies, including:
- Intravenous fluid administration to stabilise blood pressure.
- Insulin to control blood sugar levels.
- Use of a ventilator to provide oxygen.
- Surgery to remove damaged tissues.
- Medications to increase blood pressure.
The duration and effectiveness of treatment depend on how quickly it is started, the severity of the infection, and the patient's overall health. In many cases, if sepsis is treated promptly, long-term organ damage can be avoided.
The time needed to treat sepsis varies depending on the patient and the type of infection. Generally, treatment requires at least a few days, but it may last longer if the bacteria are resistant to antibiotics. The average hospital stay for sepsis varies: about 4 to 5 days for moderate cases, 6 to7 days for severe sepsis, and 16 to 17 days for septic shock.
How to Prevent Sepsis
Taking preventive measures can significantly reduce the risk of developing sepsis. Here are some helpful tips:
- Know the symptoms of sepsis: being aware of the signs can help recognise it early.
- Getting vaccinated annually against influenza reduces the risk of complications that can lead to sepsis.
- Wash hands frequently and avoid contact with people who have colds or the flu.
- Get vaccinated against pneumococcus to prevent pneumonia, meningitis, or other infections.
- Practice good hygiene.
- Clean wounds and scratches thoroughly. Avoid picking scabs to prevent infections.
- Avoid smoking and tobacco products. Non-smokers are less likely to contract respiratory infections such as colds, flu, or pneumonia.
- Follow your doctor's instructions for managing chronic conditions. Keeping conditions like diabetes or heart disease under control reduces the risk of complications.
If you have an infection that does not improve or worsens, it is important to consult your GP or other healthcare professional.